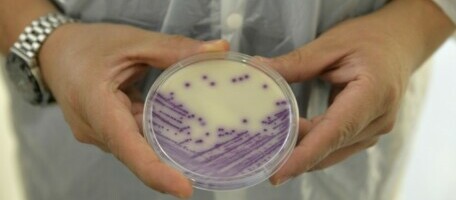

Το Transmune® σταματά την επαναμόλυνση και προστατεύει έναντι όλων των στελεχών της νόσου του Gumboro

Το εμβόλιο
Το Transmune® είναι ένα εμβόλιο ανοσοσυμπλόκων για τη νόσο του Gumboro που αποτελείται από το στέλεχος Winterfield 2512 συνδεδεμένο με ειδικά αντισώματα που λέγονται ανοσοσφαιρίνες προστατευτικές έναντι του ιού, για χορήγηση στο εκκολαπτήριο

Το προϊόν αναπτύχθηκε στις αρχές του 2000, και γρήγορα εγκρίθηκε σε πολλές χώρες ανά τον κόσμο. Σήμερα, το εμβόλιο είναι εγγεγραμμένο σε περισσότερες από 75 χώρες παγκόσμια.
Πώς λειτουργεί το ανοσοσύμπλοκο
Η έναρξη της ανοσίας από το ανοσοσύμπλοκο προσαρμόζεται στο επίπεδο των μητρικών αντισωμάτων
Ηρεμία
Σταματά τον κύκλο του Gumboro
Σταθερότητα
Σμήνη με ομοιόμορφα αποτελέσματα
Εμπιστοσύνη
Ισχυρή συνεργασία μεταξύ παραγωγών και Ceva χρόνο με το χρόνο
Ηρεμία σταματώντας το κύκλο του Gumboro.
Απομόνωση στελεχών (%) μεταξύ διαφορετικών εμβολιακών προγραμμάτων σε 4 χρόνια (2013-2016), σε 527 σμήνη.
Η σταθερότητα του Transmune® προστατεύει το θύλακο έναντι άλλων στελεχών του Gumboro.
Σταθερότητα σε ομοιόμορφα αποτελέσματα
Transmune®
Μέσοι τίτλοι του Gumboro σε σμήνη εμβολιασμένα με Transmune®. Συνολικά δείγματα: 702 σμήνη.
Πόσιμο νερό
Μέσοι τίτλοι Gumboro σε σμήνη εμβολιασμένα με εμβόλια νερού. Συνολικά δείγματα : 336 σμήνη.
rHVT-VP2
Μέσοι τίτλοι Gumboro σε σμήνη εμβολιασμένα με rHVT-VP2. Συνολικά δείγματα :134 σμήνη.
ΕΜΠΙΣΤΟΣΥΝΗ μέσω υψηλών αποδόσεων

Το εμβόλιο
Τεστ μολυσματικής δόσης νεοσσού.
Από όταν το Transmune εγκρίθηκε στην Ευρώπη μια μοναδική διαδικασία ποιοτικού ελέγχου έπρεπε να αναπτυχθεί ώστε να εξασφαλίσει την ασφάλεια και την αποτελεσματικότητα του εμβολίου.
Κάθε παρτίδα παραγωγής ελέγχεται με την εξέταση της μέσης μολυσματικής δόσης νεοσσού .
Αυτή η εξέταση χρησιμοποιείται με ένα τελικό ανάμεικτο προϊόν για να εξασφαλιστεί η δραστικότητα και η ασφάλεια του εμβολίου.

Οι υπηρεσίες μας
Έλεγχος της νόσου του Gumboro από το εκκολαπτήριο
Η νόσος του Gumboro είναι μια υψηλής μεταδοτικότητας νόσος στα νερά ορνίθια που προκαλείται από τον ιό IBDV.